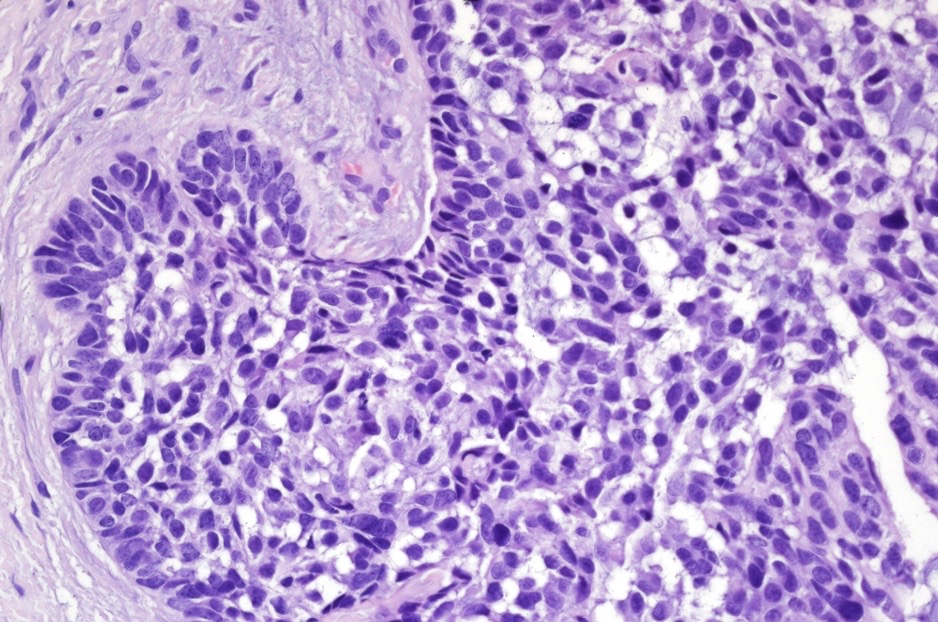
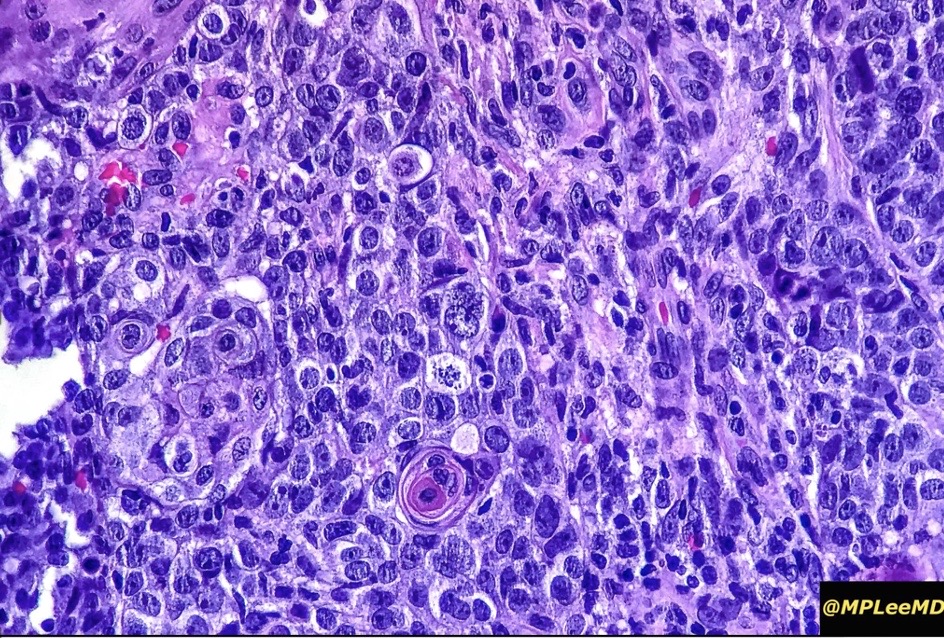
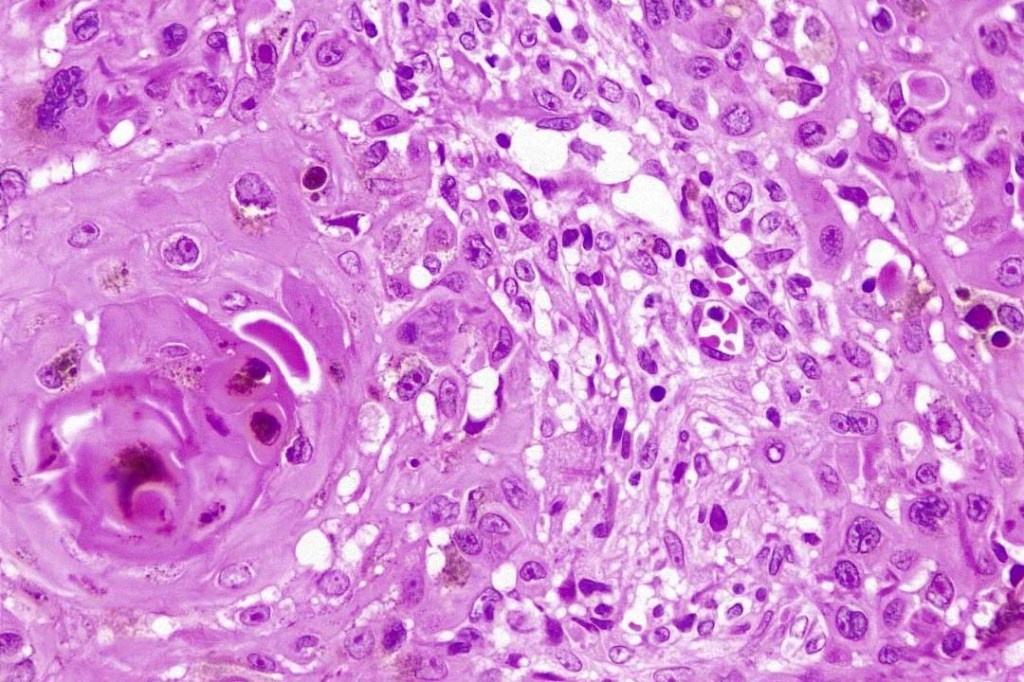

An exceedingly rare collision tumor composed of an admixture of squamous cell carcinoma/basal cell carcinoma/trichoblastoma respectively and melanoma. Although most appear to have behaved in a benign fashion, a malignant basomelanocytic tumor is illustrated below. More cases will be need to be stidies/published before the true biological behavior of this group of tumors can be satisfactorily elucidated. I think that complete excision should be the rule and a careful follow-up recomended.
Clinical features
•Elderly males (32-98)
•Sun-damaged skin of head & neck presenting as a keratotic papule or nodule
•Most cases appear to be indolent but a rare malignant basomelanocytic tumor example has been documented
Basomelanocytic tumor

Squamomelanocytic tumor

Leave a comment